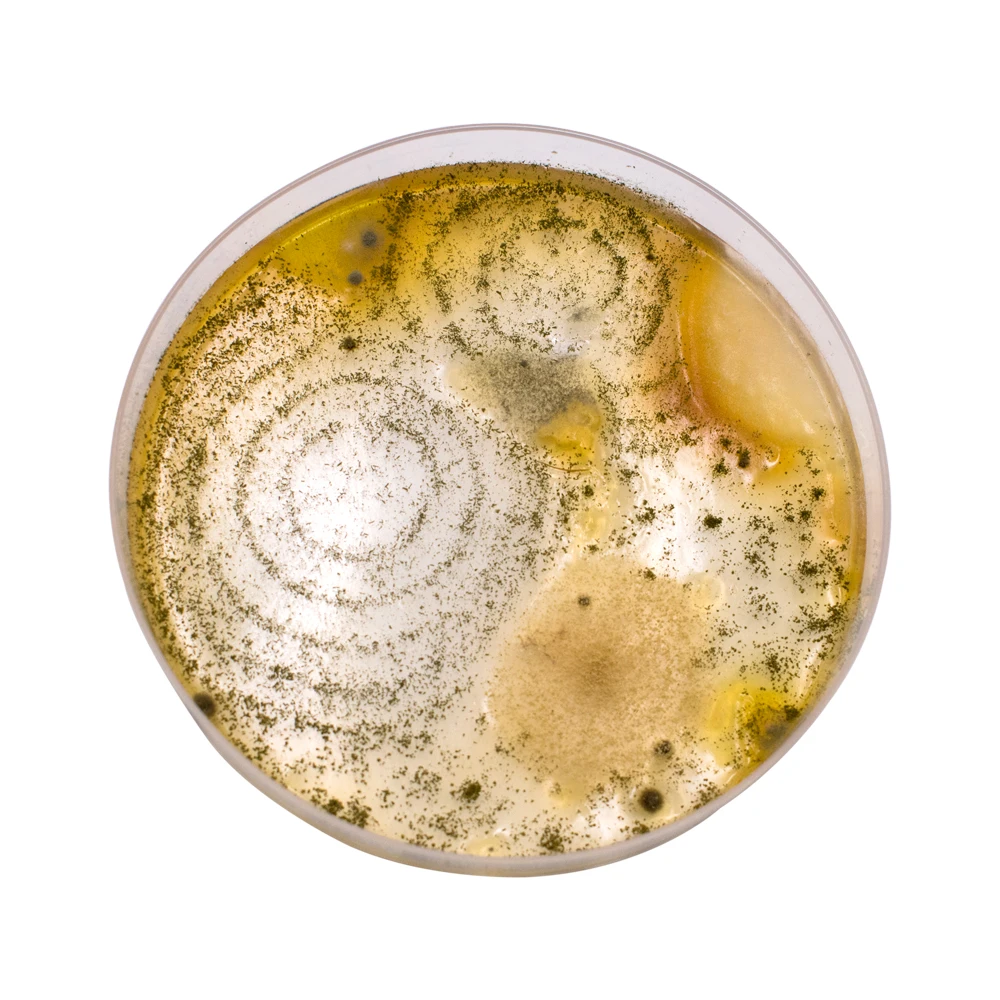

Big Bang SCIENCE лидер продаж Шпионские игрушки набор химии развивающие для
- Категория: Другие игрушки и товары для хобби >>>
- Поставщик: Xinxiang,Alpha,Manufacturing,Ltd.
Поделиться:
Описание и отзывы
Трекер стоимости
| Месяц | Минимальная цена | Макс. стоимость |
|---|---|---|
| Sep-17-2025 | 707.7 $* | 742.80 $* |
| Aug-17-2025 | 701.20 $* | 736.23 $* |
| Jul-17-2025 | 588.74 $* | 617.54 $* |
| Jun-17-2025 | 689.88 $* | 723.47 $* |
| May-17-2025 | 600.88 $* | 630.43 $* |
| Apr-17-2025 | 677.18 $* | 711.73 $* |
| Mar-17-2025 | 671.72 $* | 705.82 $* |
| Feb-17-2025 | 665.68 $* | 698.79 $* |
| Jan-17-2025 | 659.89 $* | 692.26 $* |
Характеристики
Характеристики
| Порт: | Guangzhou, Ningbo, Shanghai, Qingdao, Tianjin |
| Условия оплаты: | L/C,D/A,D/P,T/T,Western Union,MoneyGram |
| Наименование: | Big Bang SCIENCE |
| Description: | Pretend Educational Toys |
| Color: | Colorful |
| Material: | Eco-friendly |
| Модели: | SR16107 M |
| MOQ: | 1 Set |
| Function: | Developing Intelligence |
| Происхождение товара: | Henan Китай |
| Packing: | Paper Box |
| Product name: | hot sale spy toys chemistry science kit educational toys kids |
| Тип: | Прочие обучающие игрушки |
| OEM/ODM: | Acceptble |
| Age: | 8+ Kids |
| Certificate: | EN71/ASTM |
Похожие товары
Данные ресурс не является интернет-магазином, а лишь содержит ссылки на международную торговую площадку Alibaba.com